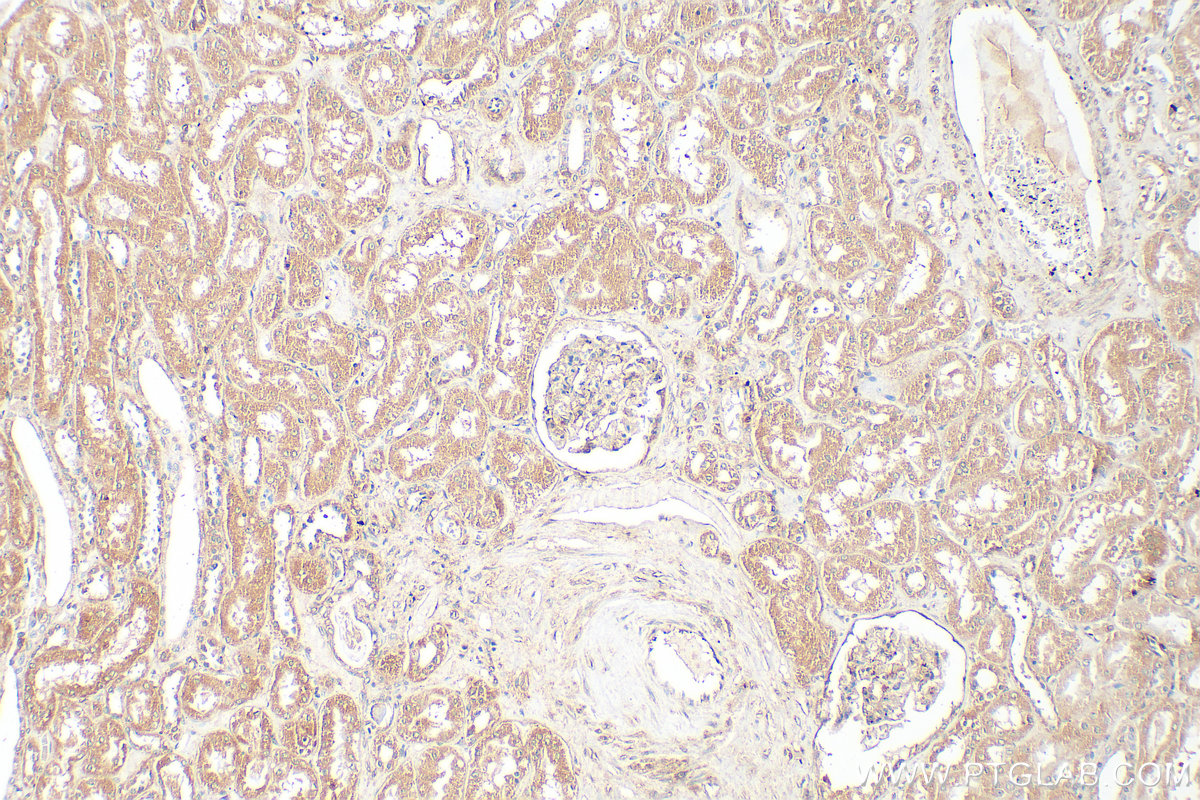
Immunohistochemical analysis of paraffin-embedded human kidney tissue slide using 20466-1-AP (INF2 antibody) at dilution of 1:400 (under 10x lens). Heat mediated antigen retrieval with Tris-EDTA buffer (pH 9.0). IHC staining of human kidney using 20466-1-AP

验证数据展示
经过测试的应用
| Positive WB detected in | A431 cells, HepG2 cells, NIH/3T3 cells, HeLa cells, PC-3 cells, K-562 cells |
| Positive IP detected in | NIH/3T3 cells |
| Positive IHC detected in | human kidney tissue Note: suggested antigen retrieval with TE buffer pH 9.0; (*) Alternatively, antigen retrieval may be performed with citrate buffer pH 6.0 |
| Positive IF/ICC detected in | HepG2 cells |
推荐稀释比
| 应用 | 推荐稀释比 |
|---|---|
| Western Blot (WB) | WB : 1:1000-1:4000 |
| Immunoprecipitation (IP) | IP : 0.5-4.0 ug for 1.0-3.0 mg of total protein lysate |
| Immunohistochemistry (IHC) | IHC : 1:200-1:800 |
| Immunofluorescence (IF)/ICC | IF/ICC : 1:200-1:800 |
| It is recommended that this reagent should be titrated in each testing system to obtain optimal results. | |
| Sample-dependent, Check data in validation data gallery. | |
产品信息
20466-1-AP targets INF2 in WB, IHC, IF/ICC, IP, CoIP, ELISA applications and shows reactivity with human, mouse samples.
| 经测试应用 | WB, IHC, IF/ICC, IP, ELISA Application Description |
| 文献引用应用 | WB, IHC, IF, IP, CoIP |
| 经测试反应性 | human, mouse |
| 文献引用反应性 | human, mouse, zebrafish |
| 免疫原 |
CatNo: Ag14302 Product name: Recombinant human INF2 protein Source: e coli.-derived, PGEX-4T Tag: GST Domain: 1-350 aa of BC008756 Sequence: MVRPKAQLVLAACESLLTSRQLPIFCQLILRIGNFLNYGSHTGDADGFKISTLLKLTETKSQQNRVTLLHHVLEEAEKSHPDLLQLPRDLEQPSQAAGINLEIIRSEASSNLKKLLETERKVSASVAEVQEQYTERLQASISAFRALDELFEAIEQKQRELADYLCEDAQQLSLEDTFSTMKAFRDLFLRALKENKDRKEQAAKAERRKQQLAEEEARRPRGEDGKPVRKGPGKQEEVCVIDALLADIRKGFQLRKTARGRGDTDGGSKAASMDPPRATEPVATSNPAGDPVGSTRCPASEPGLDATTASESRGWDLVDAVTPGPQPTLEQLEEGGPRPLERRSSWYVDA 种属同源性预测 |
| 宿主/亚型 | Rabbit / IgG |
| 抗体类别 | Polyclonal |
| 产品类型 | Antibody |
| 全称 | inverted formin, FH2 and WH2 domain containing |
| 别名 | C14orf151, C14orf173, HBEBP2 binding protein C, HBEBP2-binding protein C, Inverted formin 2 |
| 计算分子量 | 1249 aa, 136 kDa |
| 观测分子量 | 180-200 kDa |
| GenBank蛋白编号 | BC008756 |
| 基因名称 | INF2 |
| Gene ID (NCBI) | 64423 |
| RRID | AB_10694821 |
| 偶联类型 | Unconjugated |
| 形式 | Liquid |
| 纯化方式 | Antigen affinity purification |
| UNIPROT ID | Q27J81 |
| 储存缓冲液 | PBS with 0.02% sodium azide and 50% glycerol, pH 7.3. |
| 储存条件 | Store at -20°C. Stable for one year after shipment. Aliquoting is unnecessary for -20oC storage. |
背景介绍
INF2 is a member of the formin family of actin-regulating proteins. INF2 is peripherally bound to the cytoplasmic face of the endoplasmic reticulum (ER). Mutations in the formin gene INF2 cause focal segmental glomerulosclerosis. The predicted MW of INF2 is around 136 kDa, while higher molecular mass from 140-200 kDa has been reported in literature (26383224,20493814,19366733).
实验方案
| Product Specific Protocols | |
|---|---|
| IF protocol for INF2 antibody 20466-1-AP | Download protocol |
| IHC protocol for INF2 antibody 20466-1-AP | Download protocol |
| IP protocol for INF2 antibody 20466-1-AP | Download protocol |
| WB protocol for INF2 antibody 20466-1-AP | Download protocol |
| Standard Protocols | |
|---|---|
| Click here to view our Standard Protocols |
发表文章
| Species | Application | Title |
|---|---|---|
Cell FMN2 Makes Perinuclear Actin to Protect Nuclei during Confined Migration and Promote Metastasis. | ||
Nat Commun GPCR-induced calcium transients trigger nuclear actin assembly for chromatin dynamics. | ||
J Nanobiotechnology Oxygen-delivery nanoparticles enhanced immunotherapy efficacy monitored by granzyme B PET imaging in malignant tumors | ||
Proc Natl Acad Sci U S A Inverted formin 2 in focal adhesions promotes dorsal stress fiber and fibrillar adhesion formation to drive extracellular matrix assembly. | ||
Proc Natl Acad Sci U S A Mechanical stimulation induces formin-dependent assembly of a perinuclear actin rim.
|